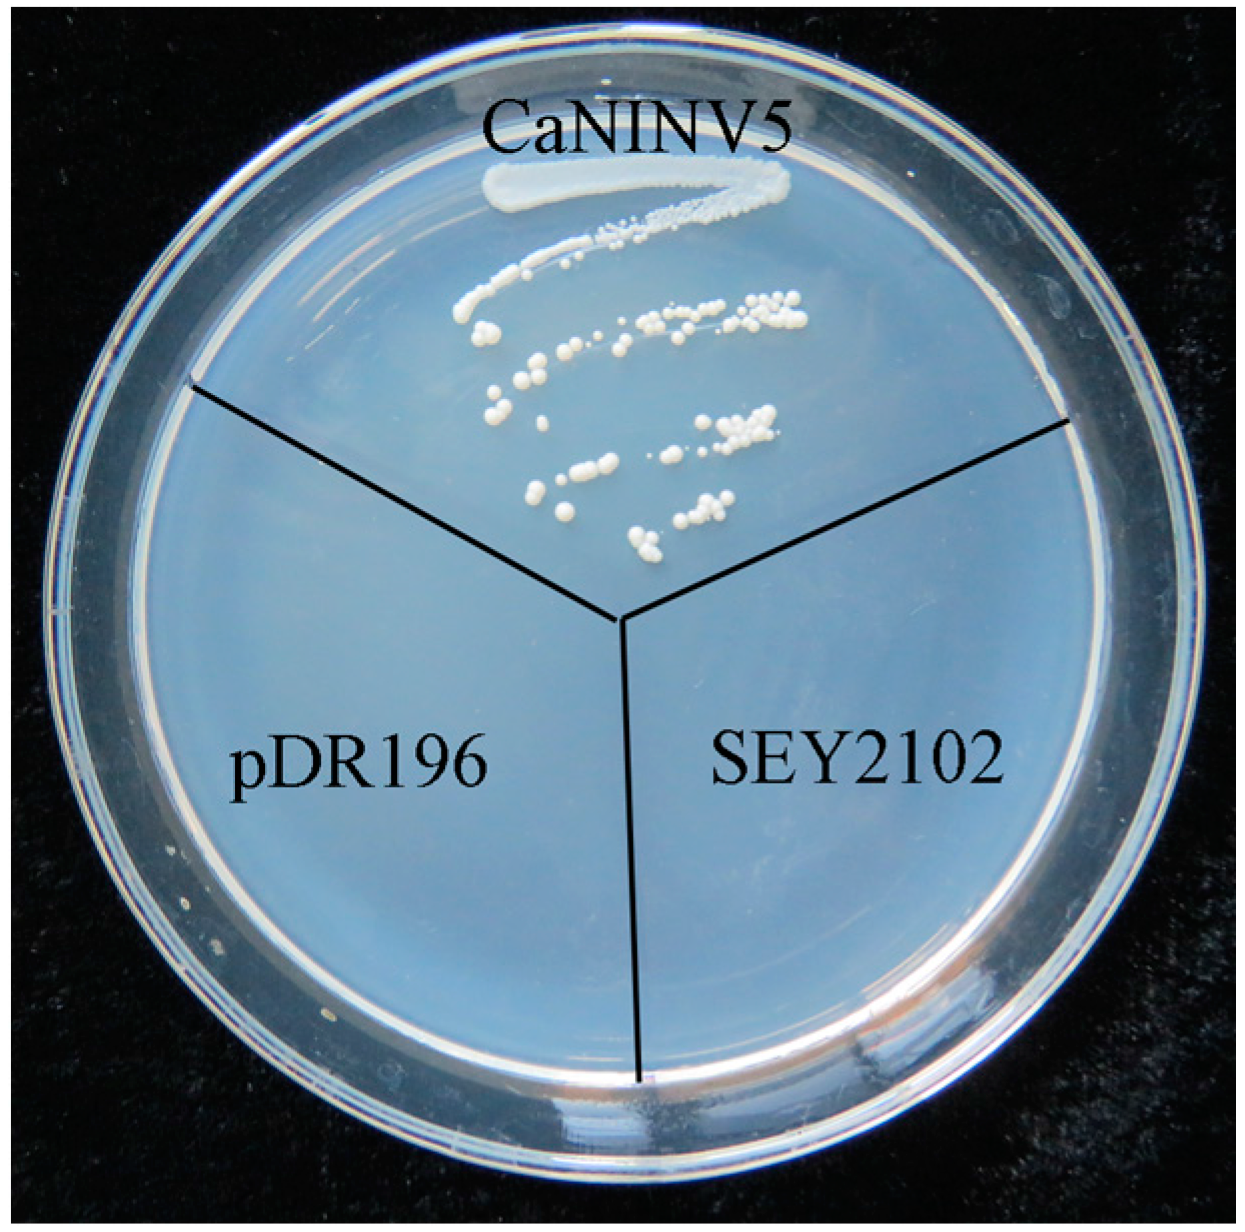
Ijms 19 00224 g009

Genome-Wide Identification, Expression, and Functional Analysis of the Alkaline/Neutral Invertase Gene Family in Pepper
Abstract
1. Introduction
2. Results
2.1. Identification and Characterization of CaNINV Genes in Pepper
2.2. Phylogenetic Analysis of CaNINV Genes
2.3. Structure Analysis and Chromosomal Distribution of the CaNINV Family Genes
2.4. Motif Distribution in CaNINV Proteins
2.5. Three-Dimensional Structure of CaNINV Proteins
2.6. Expression Analysis of CaNINV Genes for Different Tissues and Developmental Stages
2.7. Yeast Complementation of CaNINV5
2.8. Optimum pH Determination for CaNINV5
3. Discussion
3.1. Identification and Characterization of CaNINV Genes
3.2. Differential Expression and Enzymatic Activities of CaNINVs
4. Materials and Methods
4.1. Plant Materials
4.2. Identification and Sequence Analysis of CaNINV Proteins in Pepper
4.3. Phylogenetic Analyses
4.4. Exon–Intron Structure Analysis and Chromosomal Mapping
4.5. Conserved Motif Analysis
4.6. Prediction of Three-Dimensional Structure of the CaNINV Proteins
4.7. Pepper RNA-Seq Data Analysis
4.8. Cloning of Full-Length CaNINV5
4.9. Yeast Complementation and Enzymatic Analysis of CaNINV5
Acknowledgments
Author Contributions
Conflicts of Interest
References
- Qin, G.; Zhu, Z.; Wang, W.; Cai, J.; Chen, Y.; Li, L.; Tian, S. A tomato vacuolar invertase inhibitor mediates sucrose metabolism and influences fruit ripening. Plant Physiol. 2016, 172, 1596–1611. [Google Scholar] [CrossRef] [PubMed]
- Zhang, H.P.; Wu, J.Y.; Qin, G.H.; Yao, G.F.; Qi, K.J.; Wang, L.F.; Zhang, S.L. The role of sucrose-metabolizing enzymes in pear fruit that differ in sucrose accumulation. Acta Physiol. Plant. 2014, 36, 71–77. [Google Scholar] [CrossRef]
- Chen, C.; Yuan, Y.; Zhang, C.; Li, H.; Ma, F.; Li, M. Sucrose phloem unloading follows an apoplastic pathway with high sucrose synthase in actinidia fruit. Plant Sci. 2017, 255, 40–50. [Google Scholar] [CrossRef] [PubMed]
- Oury, V.; Caldeira, C.F.; Prodhomme, D.; Pichon, J.P.; Gibon, Y.; Tardieu, F.; Turc, O. Is change in ovary carbon status a cause or a consequence of maize ovary abortion in water deficit during flowering? Plant Physiol. 2016, 171, 997–1008. [Google Scholar] [CrossRef] [PubMed]
- Ruan, Y.L. Sucrose metabolism: Gateway to diverse carbon use and sugar signaling. Annu. Rev. Plant Biol. 2014, 65, 33–67. [Google Scholar] [CrossRef] [PubMed]
- Bieniawska, Z.; Paul Barratt, D.H.; Garlick, A.P.; Thole, V.; Kruger, N.J.; Martin, C.; Zrenner, R.; Smith, A.M. Analysis of the sucrose synthase gene family in Arabidopsis. Plant J. 2007, 49, 810–828. [Google Scholar] [CrossRef] [PubMed]
- Fotopoulos, V. Plant invertases: Structure, function and regulation of a diverse enzyme family. J. Biol. Res. 2005, 4, 127–137. [Google Scholar]
- Roitsch, T.; González, M.C. Function and regulation of plant invertases: Sweet sensations. Trends Plant Sci. 2004, 9, 606–613. [Google Scholar] [CrossRef] [PubMed]
- Vargas, W.A.; Salerno, G.L. The cinderella story of sucrose hydrolysis: Alkaline/neutral invertases, from cyanobacteria to unforeseen roles in plant cytosol and organelles. Plant Sci. 2010, 178, 1–8. [Google Scholar] [CrossRef]
- Sturm, A. Invertases. Primary structures, functions, and roles in plant development and sucrose partitioning. Plant Physiol. 1999, 121, 1–8. [Google Scholar] [CrossRef] [PubMed]
- Roitsch, T.; Balibrea, M.E.; Hofmann, M.; Proels, R.; Sinha, A.K. Extracellular invertase: Key metabolic enzyme and PR protein. J. Exp. Bot. 2003, 54, 513–524. [Google Scholar] [CrossRef] [PubMed]
- Proels, R.K.; Hückelhoven, R. Cell-wall invertases, key enzymes in the modulation of plant metabolism during defence responses. Mol. Plant Pathol. 2014, 15, 858–864. [Google Scholar] [CrossRef] [PubMed]
- Wang, L.; Cook, A.; Patrick, J.W.; Chen, X.Y.; Ruan, Y.L. Silencing the vacuolar invertase gene GHVIN1 blocks cotton fiber initiation from the ovule epidermis, probably by suppressing a cohort of regulatory genes via sugar signaling. Plant J. 2014, 78, 686–696. [Google Scholar] [CrossRef] [PubMed]
- Tang, G.Q.; Luscher, M.; Sturm, A. Antisense repression of vacuolar and cell wall invertase in transgenic carrot alters early plant development and sucrose partitioning. Plant Cell 1999, 11, 177–189. [Google Scholar] [CrossRef] [PubMed]
- Ji, X.; Van den Ende, W.; Van Laere, A.; Cheng, S.; Bennett, J. Structure, evolution, and expression of the two invertase gene families of rice. J. Mol. Evol. 2005, 60, 615–634. [Google Scholar] [CrossRef] [PubMed]
- Bocock, P.N.; Morse, A.M.; Dervinis, C.; Davis, J.M. Evolution and diversity of invertase genes in Populus trichocarpa. Planta 2008, 227, 565–576. [Google Scholar] [CrossRef] [PubMed]
- Yao, Y.; Geng, M.T.; Wu, X.H.; Liu, J.; Li, R.M.; Hu, X.W.; Guo, J.C. Genome-wide identification, expression, and activity analysis of alkaline/neutral invertase gene family from cassava (Manihot esculenta crantz). Plant Mol. Biol. Report. 2015, 33, 304–315. [Google Scholar] [CrossRef]
- Nonis, A.; Ruperti, B.; Pierasco, A.; Canaguier, A.; Adam-Blondon, A.F.; di Gaspero, G.; Vizzotto, G. Neutral invertases in grapevine and comparative analysis with Arabidopsis, poplar and rice. Planta 2008, 229, 129–142. [Google Scholar] [CrossRef] [PubMed]
- Welham, T.; Pike, J.; Horst, I.; Flemetakis, E.; Katinakis, P.; Kaneko, T.; Sato, S.; Tabata, S.; Perry, J.; Parniske, M. A cytosolic invertase is required for normal growth and cell development in the model legume, Lotus japonicus. J. Exp. Bot. 2009, 60, 3353–3365. [Google Scholar] [CrossRef] [PubMed]
- Liu, S.; Lan, J.; Zhou, B.; Qin, Y.; Zhou, Y.; Xiao, X.; Yang, J.; Gou, J.; Qi, J.; Huang, Y. HbNIN2, a cytosolic alkaline/neutral-invertase, is responsible for sucrose catabolism in rubber-producing laticifers of Hevea brasiliensis (para rubber tree). New Phytol. 2015, 206, 709–725. [Google Scholar] [CrossRef] [PubMed]
- Rende, U.; Wang, W.; Gandla, M.L.; Jönsson, L.J.; Niittylä, T. Cytosolic invertase contributes to the supply of substrate for cellulose biosynthesis in developing wood. New Phytol. 2017, 214, 796–807. [Google Scholar] [CrossRef] [PubMed]
- Dahro, B.; Wang, F.; Peng, T.; Liu, J.H. PtrA/NINV, an alkaline/neutral invertase gene of Poncirus trifoliata, confers enhanced tolerance to multiple abiotic stresses by modulating ROS levels and maintaining photosynthetic efficiency. BMC Plant Biol. 2016, 16, 76. [Google Scholar] [CrossRef] [PubMed]
- Liu, J.; Han, L.; Huai, B.; Zheng, P.; Chang, Q.; Guan, T.; Li, D.; Huang, L.; Kang, Z. Down-regulation of a wheat alkaline/neutral invertase correlates with reduced host susceptibility to wheat stripe rust caused by Puccinia striiformis. J. Exp. Bot. 2015, 66, 7325–7338. [Google Scholar] [CrossRef] [PubMed]
- Yao, S.G.; Kodama, R.; Wang, H.; Ichii, M.; Taketa, S.; Yoshida, H. Analysis of the rice SHORT-ROOT5 gene revealed functional diversification of plant neutral/alkaline invertase family. Plant Sci. 2009, 176, 627–634. [Google Scholar] [CrossRef]
- Martín, M.L.; Lechner, L.; Zabaleta, E.J.; Salerno, G.L. A mitochondrial alkaline/neutral invertase isoform (A/N-InvC) functions in developmental energy-demanding processes in Arabidopsis. Planta 2013, 237, 813–822. [Google Scholar] [CrossRef] [PubMed]
- Elwan, M.W.M.; El-Hamahmy, M.A.M. Improved productivity and quality associated with salicylic acid application in greenhouse pepper. Sci. Hortic. 2009, 122, 521–526. [Google Scholar] [CrossRef]
- Hubbard, N.L.; Pharr, D.M. Developmental changes in carbohydrate concentration and activaties of sucrose metabolizing enzymes in fruits of two Capsicum annuum L. genotypes. Plant Sci. 1992, 86, 33–39. [Google Scholar] [CrossRef]
- Aloni, B.; Karni, L.; Zaidman, Z.; Schaffer, A.A. Changes of carbohydrates in pepper (Capsicum annuum L.) flowers in relation to their abscission under different shading regimes. Ann. Bot. 1996, 78, 163–168. [Google Scholar] [CrossRef]
- Marcelis, L.F.; Heuvelink, E.; Hofman-Eijer, L.R.; Bakker, J.D.; Xue, L.B. Flower and fruit abortion in sweet pepper in relation to source and sink strength. J. Exp. Bot. 2004, 55, 2261–2268. [Google Scholar] [CrossRef] [PubMed]
- Qin, C.; Yu, C.; Shen, Y.; Fang, X.; Chen, L.; Min, J.; Cheng, J.; Zhao, S.; Xu, M.; Luo, Y. Whole-genome sequencing of cultivated and wild peppers provides insights into Capsicum domestication and specialization. Proc. Natl. Acad. Sci. USA 2014, 111, 5135–5140. [Google Scholar] [CrossRef] [PubMed]
- Li, M.; Feng, F.; Cheng, L. Expression patterns of genes involved in sugar metabolism and accumulation during apple fruit development. PLoS ONE 2012, 7, e33055. [Google Scholar] [CrossRef] [PubMed]
- Wang, X.; Chang, L.; Tong, Z.; Wang, D.; Yin, Q.; Wang, D.; Jin, X.; Yang, Q.; Wang, L.; Sun, Y. Proteomics profiling reveals carbohydrate metabolic enzymes and 14-3-3 proteins play important roles for starch accumulation during cassava root tuberization. Sci. Rep. 2016, 6, 19643. [Google Scholar] [CrossRef] [PubMed]
- Sheffield, J.; Taylor, N.C.; Chen, S. The cassava (Manihot esculenta Crantz) root proteome: Protein identification and differential expression. Proteomics 2006, 6, 1588–1598. [Google Scholar] [CrossRef] [PubMed]
- Xie, J.; Cai, K.; Hu, H.X.; Jiang, Y.L.; Yang, F.; Hu, P.F.; Cao, D.D.; Li, W.F.; Chen, Y.; Zhou, C.Z. Structural analysis of the catalytic mechanism and substrate specificity of Anabaena alkaline invertase inva reveals a novel glucosidase. J. Biol. Chem. 2016, 291, 25667–25677. [Google Scholar] [CrossRef] [PubMed]
- Pan, Y.; Bradley, G.; Pyke, K.; Ball, G.; Lu, C.; Fray, R.; Marshall, A.; Jayasuta, S.; Baxter, C.; Van, W.R. Network inference analysis identifies an APRR2-like gene linked to pigment accumulation in tomato and pepper fruits. Plant Physiol. 2013, 161, 1476–1485. [Google Scholar] [CrossRef] [PubMed]
- Qi, X.; Wu, Z.; Li, J.; Mo, X.; Wu, S.; Chu, J.; Wu, P. AtCYT-INV1, a neutral invertase, is involved in osmotic stress-induced inhibition on lateral root growth in Arabidopsis. Plant Mol. Biol. 2007, 64, 575–587. [Google Scholar] [CrossRef] [PubMed]
- Xiang, L.; le Roy, K.; Bolouri-Moghaddam, M.R.; Vanhaecke, M.; Lammens, W.; Rolland, F.; van den Ende, W. Exploring the neutral invertase-oxidative stress defence connection in Arabidopsis thaliana. J. Exp. Bot. 2011, 62, 3849–3862. [Google Scholar] [CrossRef] [PubMed]
- Vargas, W.A.; Pontis, H.G.; Salerno, G.L. Differential expression of alkaline and neutral invertases in response to environmental stresses: Characterization of an alkaline isoform as a stress-response enzyme in wheat leaves. Planta 2007, 226, 1535–1545. [Google Scholar] [CrossRef] [PubMed]
- Hu, B.; Jin, J.; Guo, A.Y.; Zhang, H.; Luo, J.; Gao, G. GSDS 2.0: An upgraded gene feature visualization server. Bioinformatics 2015, 31, 1296–1297. [Google Scholar] [CrossRef] [PubMed]

| Gene Name | Gene ID | ORF Length (bp) | Protein Length (aa) | MW (kDa) | PI | Localization |
|---|---|---|---|---|---|---|
| CaNINV1 | Capana05g002151 | 1788 | 595 | 67.84 | 6.04 | Mitochondria and/or plastid |
| CaNINV2 | Capana11g000243 | 1926 | 641 | 72.77 | 6.94 | Plastid |
| CaNINV3 | Capana12g002379 | 1968 | 655 | 73.57 | 6.18 | Plastid |
| CaNINV4 | Capana06g001364 | 1656 | 551 | 62.98 | 6.07 | |
| CaNINV5 | Capana04g000213 | 1713 | 570 | 65.18 | 6.02 | |
| CaNINV6 | Capana08g002679 | 1707 | 568 | 65.09 | 6.35 | |
| CaNINV7 | Capana08g000259 | 861 | 286 | 32.49 | 7.07 |
© 2018 by the authors. Licensee MDPI, Basel, Switzerland. This article is an open access article distributed under the terms and conditions of the Creative Commons Attribution (CC BY) license (http://creativecommons.org/licenses/by/4.0/).
Share and Cite
Shen, L.-B.; Yao, Y.; He, H.; Qin, Y.-L.; Liu, Z.-J.; Liu, W.-X.; Qi, Z.-Q.; Yang, L.-J.; Cao, Z.-M.; Yang, Y. Genome-Wide Identification, Expression, and Functional Analysis of the Alkaline/Neutral Invertase Gene Family in Pepper. Int. J. Mol. Sci. 2018, 19, 224. https://doi.org/10.3390/ijms19010224
Shen L-B, Yao Y, He H, Qin Y-L, Liu Z-J, Liu W-X, Qi Z-Q, Yang L-J, Cao Z-M, Yang Y. Genome-Wide Identification, Expression, and Functional Analysis of the Alkaline/Neutral Invertase Gene Family in Pepper. International Journal of Molecular Sciences. 2018; 19(1):224. https://doi.org/10.3390/ijms19010224
Chicago/Turabian StyleShen, Long-Bin, Yuan Yao, Huang He, Yu-Ling Qin, Zi-Ji Liu, Wei-Xia Liu, Zhi-Qiang Qi, Li-Jia Yang, Zhen-Mu Cao, and Yan Yang. 2018. "Genome-Wide Identification, Expression, and Functional Analysis of the Alkaline/Neutral Invertase Gene Family in Pepper" International Journal of Molecular Sciences 19, no. 1: 224. https://doi.org/10.3390/ijms19010224
APA StyleShen, L.-B., Yao, Y., He, H., Qin, Y.-L., Liu, Z.-J., Liu, W.-X., Qi, Z.-Q., Yang, L.-J., Cao, Z.-M., & Yang, Y. (2018). Genome-Wide Identification, Expression, and Functional Analysis of the Alkaline/Neutral Invertase Gene Family in Pepper. International Journal of Molecular Sciences, 19(1), 224. https://doi.org/10.3390/ijms19010224
